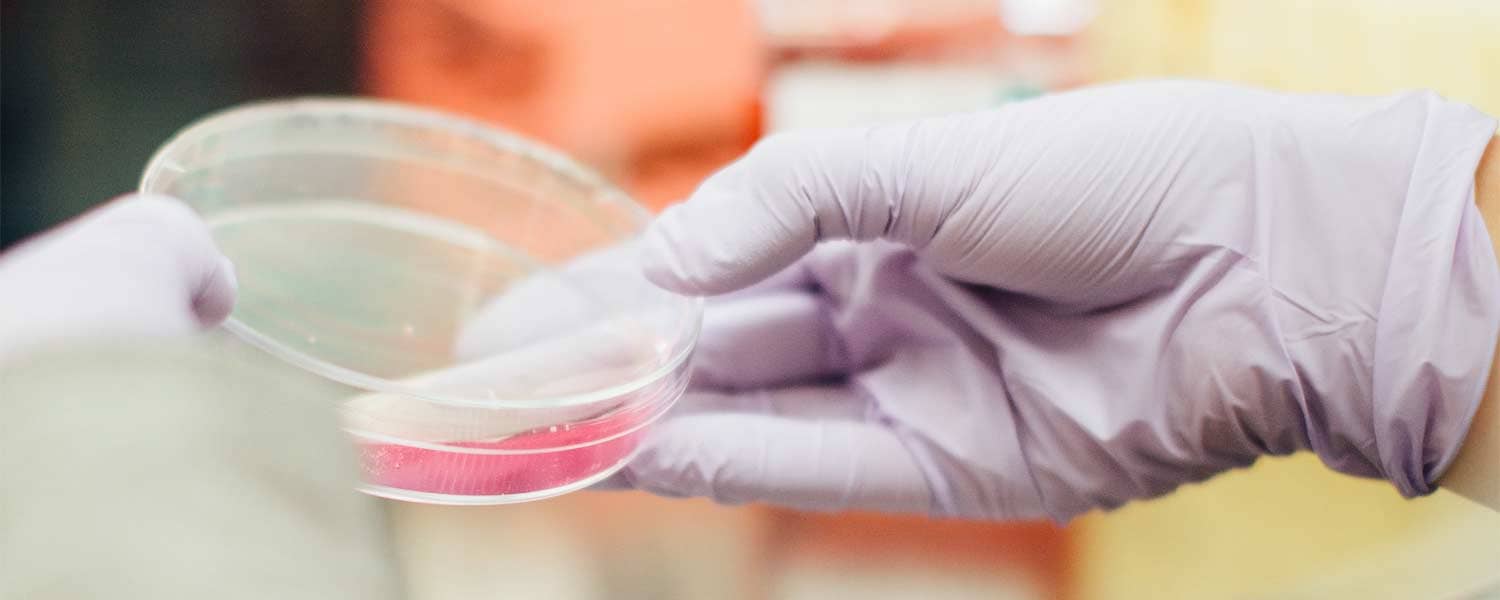
Closeup of a specimen in a petrie dish

Master’s of Public Health Online

Request more information!
Advance your career in healthcare with an MPH degree
- 100% online
- 6 start dates
- No GRE/GMAT required
- 7‑week terms
- 3 concentrations
- 15 month accelerated option*
* Program length may vary by individual
Become profession ready with marketable skills
With three concentrations to choose from, your MPH will enable you to meet your personal and professional development goals. Our online master’s degree in Public Health will provide you with the knowledge to build a successful career in healthcare, and give you the practical skills to pursue a new career path.
Concentrations available
- Global Health
- Community Health
- Health Policy and Management


An investment in your future
Tuition for the MPH program is competitive with other private non-profit colleges, and we break it down for you so you know exactly what you’ll pay before you start classes. Financial aid is available for those who qualify. Students entering the MPH program must meet all program admission requirements.
MPH TuitionYour career-focused MPH degree
Here, we promote inquiry, health, and well-being, as well as the development of highly skilled leaders who become public hospital administrators, policy makers, public health directors, community leaders, and more. Doctors, nurses, and other medical professionals with an interest in population health and medicine find success in our program.
Apply Now
Recognized for affordability
Goodwin University was rated among the most affordable universities in Connecticut for associate, bachelor’s, and master’s degrees.*
* Affordable Degree Guide, 2025

Download your very own master’s in Public Health guide!
We’ve prepared a special guide just for you.
Download GuideExpert faculty

Maritza Bond, MPH
Maritza Bond is a dedicated health professional experienced in local, state, and federal services and mandates. She is the new Director of Public Health in New Haven after being the Director of Public Health and Social Services for the city of Bridgeport. Her expertise includes promoting community health using policy, system, and collective impact framework.

Meg Zayan, EdD, RDH, MPH
Dr. Zayan has previously served as the dean and director of UB’s Fones School of Dental Hygiene, worked for the Colorado Migrant Health Department, the U.S. Agency for International Development, CARE International, and the U.S. State Department. She has taught online courses for 10+ years.
The benefits of two universities
This is a joint program offered by Goodwin University and University of Bridgeport. You will learn alongside fellow students from both universities and share experiences in a dynamic learning environment. Upon completion, your master’s degree will list both universities.
Named #1 college for women in CT



